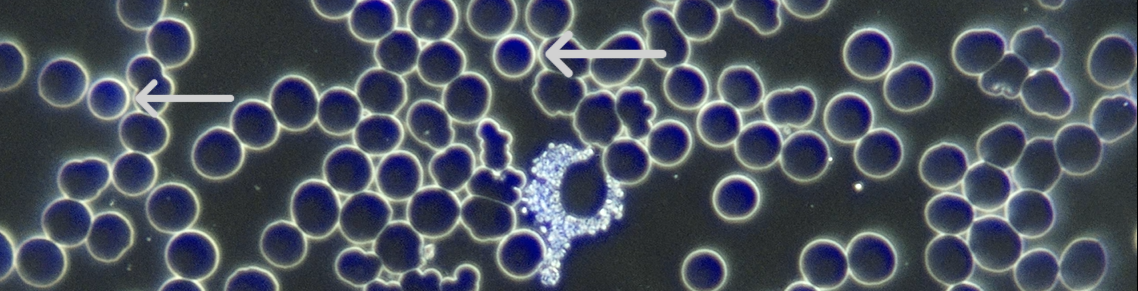

Appearance
Spherocytes are small, spherical RBCs, approximately two-thirds the diameter of normal RBCs and lack a zone of central pallor. They appear significantly darker and smaller than normal RBCs in brightfield and have a thicker and brighter cell membrane in darkfield….
Relevance
Spherocytes are not usually observed in normal live blood samples. This finding is significant when seen during analysis.
Implications
• Spherocytes are a fairly rare finding in live blood analysis. Spherocytosis occurs in immune-mediated haemolytic anaemia or from hereditary factors. • In blood analysis, finding a few spherocytes in a sample is regarded as a sign of inflammation.
Associated Symptoms
• Pain at the focus of inflammation.
• Jaundice and signs of haemolytic anaemia.
• May be asymptomatic.
Pleomorphic Perspective
These forms develop as a result of consumption of the erythrocyte’s material by the endobiont. Careful inspection of the sample will reveal that there are advanced phases of the endobiont occurring.
Medical Perspective
The spherocyte is an erythrocyte in which the biconcave disc profile is lost. It is formed when there is a defect in the membrane function. The sodium pump causes Na+ retention which increases water retention, increasing the intracellular volume. This cell is the predominant morphologic abnormality in patients with hereditary spherocytosis, autoimmune haemolytic anaemia and haemolytic transfusion reactions. It can also be observed in haemolytic states such as the Heinz body haemolytic anaemias, clostridial sepsis, hypophosphataemia (low serum phosphate concentration), toxins and traumatic injury.
Interventions
Any combination of the following, depending on the rest of the case: INFLAMMATION PROTOCOL: • HumiCaps (Neogenesis Health Products): 2–4 capsules 2–4× daily. • Curcumigen (Neogenesis Health Products): 1 capsule 1–2× daily. • Glutathione 500 (Neogenesis Health Products): 1 capsule 1–2× daily. • Trace minerals: Bio-Ionic Mineral Concentrate (Neogenesis Health Products). • Omega-3 supplement (1000–2000 mg EPA daily). GENERAL GUIDELINES: • Increase water intake. To determine necessary daily water intake (in litres): Weight (kg) / 8 × 0.25. • Reduce animal protein and acid-forming foods. • Increase intake of fibre-rich carbohydrates (those tolerated by the blood type) and raw, polyunsaturated fats. • Avoid saturated fat, refined carbohydrates, and food deficient in natural enzymes. • Avoid alcohol, caffeine, sugar, drugs, and non-essential medication. • Raw vegetable juices, sprouts, greens, and superfoods. Working with Spherocytes Spherocytes may be related to severe inflammation or immune-mediated haemolytic anaemia. Correlate clinically to determine the most likely cause. The interventions outlined above are geared towards addressing inflammation. Natural interventions to address immune-mediated haemolytic anaemia also utilize natural anti-inflammatories, in addition to Bio-Algae Concentrates (BAC), containing a mixture of Spirulina pacifica, Spirulina platensis, Dunaliella salina and astaxanthin from Haematococcus pluvialis. It is clear that the powerful antioxidant and anti-inflammatory effect of astaxanthin will have a beneficial effect in this condition.
Further Investigations
• FBC + Differential + ESR
• Liver Function Test (LFT)
• C-Reactive Protein (CRP)
• Urea, Electrolytes & Creatinine (UE+C)
 Disclaimer
Disclaimer